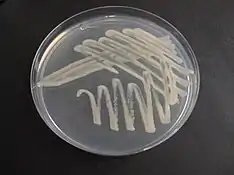

Agrobacterium rhizogenes
Agrobacterium rhizogenes (з грец. rhiza — «корінь», gennao — «створювати, продукувати») — вид грам-негативних паличкоподібних аеробних ґрунтових бактерій роду Agrobacterium, що вражають корені рослин внаслідок потрапляння бактерій у клітини через механічні пошкодження тканин. [1] На основі біологічних особливостей та здатності трансформувати рослинні клітини Argobacterium rhizogenes широко використовують у біотехнології та генній інженерії рослин. [2]
? Agrobacterium rhizogenes | ||||||||||||||
|---|---|---|---|---|---|---|---|---|---|---|---|---|---|---|
![]() ![]() Електронна мікрофотографія клітин Agrobacterium rhizogenes | ||||||||||||||
| Біологічна класифікація | ||||||||||||||
| ||||||||||||||
| Синоніми | ||||||||||||||
| Rhizobium rhizogenes
Phytomonas rhizogenes | ||||||||||||||
Посилання | ||||||||||||||
| ||||||||||||||
Історія та систематика
Вид є одним із типових представників роду Agrobacterium. Перші згадки про Agrobacterium rhizogenes у наукових працях з'явилися у 1930 році. У літературі також зустрічається назва Rhizobium rhizogenes. [1] Назва виду походить із грецької мови та базується на здатності бактерій змінювати архітектуру коренів рослин, що характеризується появою бородатих (волохатих) коренів. Дослівно «бактерії, що утворюють корені». [2] Вперше термін «волохатий корінь» згадав у своїй роботі Стюарт у 1900 році, згодом його цитував Гільдебрандт у 1934 році. У 1930 році Рікер із колегами описав організм, що викликає захворювання рослин з утворенням волохатих коренів, і назвав Phytomonas rhizogenes, згодом вид перейменували і він отримав сучасну назву. [3] Загалом до виду належать пухлинні, ризогенні та непатогенні штами. Назви типових штамів: ATCC 11325, DSM 30148, ICMP 5794, IFO 13257, LMG 150, NCPPB 2991. Номери доступу у базі GenBank на основі послідовності 16S рРНК: D01257, D14501. [1][4]
Біологічні властивості
Морфологія
Agrobacterium rhizogenes — це прямі або злегка зігнуті паличкоподібні бактерії розмірами 0,6−1,0×1,5−3,0 мкм. У полі зору мікроскопа розміщуються поодиноко або попарно. Здатні до руху за рахунок 1-4 перитрихальних джгутиків, спор не утворюють. [1]
Культуральні особливості
При культивуванні на щільних живильних середовищах бактеріальні клітини формують округлі опуклі гладкі колонії з рівними краями, позбавлені пігменту або світло-бежевого кольору. [2] Якщо у роботі використовувати вуглеводовмісні живильні середовища, навколо колоній утворюється позаклітинний полісахаридний слиз. Оптимальна температура для росту 25-28°С, при 35°С ріст відсутній. Необхідний фактор росту біотин. Рівень рН 5-9. [1]
Метаболізм
Agrobacterium rhizogenes хемоорганотрофи, здатні до утилізації пропіонату, пірувату, D-рафінози, L-серину, L-сорбози, L-треоніну, D-тагарози, ксилітолу, ксилози, гліцерату, L-лізину, D-арабінози, L-аргініну, L-аспартату, цитрату, D-фукози та глюконату. Представники виду кетолактозонегативні, оксидазо- та уреазопозитивні. Індол не продукують. Результати тестів біохімічної активності виду є диференційними. [1] Для A. rhizogenes характерний метаболізм опінів. Комплексні опінові кислоти маннопін та агропінову кислоту бактерії використовують як джерело вуглецю та азоту. [2]
Патогенність для рослин
Agrobacterium rhizogenes індукують пухлинний ріст рослинних клітин, які називають бородатими, або волохатими коренями. За будовою такі корені відрізняються від здорових наявністю більшої кількості кореневих волосків, вони довші, ніж зазвичай. Вони здатні швидко рости за відсутності екзогенних регуляторів росту. Коренева система розвивається загалом більш розгалуженою і є агравітропною. Утворення таких коренів спричинене перенесенням фрагменту ДНК бактерій у ядерний геном рослинних клітин (Т-ДНК). Експресія генів, що закодовані у цій послідовності, сприяє розвитку та утворенню коренів у ділянці зараження рослин. [5]
Патогенність штамів виду A. rhizogenes визначають за наявністю певного типу плазміди. Пухлиногенні штами містять Ті плазміду, ризогенні штами - Ri плазміду, а штами, які не містять цих плазмід, є непатогенними. Усі перелічені штами разом формують A. radiobacter біовар rhizogenes (біотип 2). Здатність Ri штамів A. rhizogenes індукувати утворення коренів перевіряють за допомогою аналізу із використанням морквяного диска. Проте результати таких експериментів можуть бути хибнопозитивними, тому що пухлинні штами можуть індукувати ріст волохатих коренів у деяких видів рослин. [1] Ri плазміда складається з різних сегментів, а розмір сягає 10-30 тисяч пар основ. [3]
Рослини-господарі
Кількість природних господарів A. rhizogenes обмежена. Найчастіше бактерії вражають види яблунь, огірків, помідорів або динь. Проте у лабораторних умовах виявлено понад 450 видів дводольних та однодольних рослин, які вразливі до інфікування A. rhizogenes. Також проводяться дослідження із голонасінними. [5]
Використання в генній інженерії та біотехнології рослин
Бородаті корені, які утворюють A. rhizogenes, використовують як інструмент для трансгенезу з метою виробництва метаболітів та вивчення функцій генів у рослин. Перевагою використання культур волохатих коренів є утворення значної біомаси. Прикладом практичного застосування є використання білків і вторинних метаболітів, які продукують культури волохатих коренів, для детоксикації забрудненого навколишнього середовища та підвищення посухостійкостірослин. Взаємодію A. rhizogenes з різними видами рослин, типами тканин та конкретними органами або окремими частинами активно вивчають, заражаючи листя, стебла, черешки, верхівкові пагони, сім'ядолі, протопласти, корені і бульби. Порівняння результатів дає розуміння здатності бактерій до зараження та генетичної трансформації. [3] [5]
Джерела
- Young, John M.; Kerr, Allen; Sawada, Hiroyuki (2015). Agrobacterium. Bergey's Manual of Systematics of Archaea and Bacteria (англ.). John Wiley & Sons, Ltd. с. 1–15. ISBN 978-1-118-96060-8. doi:10.1002/9781118960608.gbm00842.
- Rhizobium rhizogenes. SANBI (амер.). Процитовано 5 грудня 2021.
- Chandra, Sheela (2012-03). Natural plant genetic engineer Agrobacterium rhizogenes: role of T-DNA in plant secondary metabolism. Biotechnology Letters (англ.) 34 (3). с. 407–415. ISSN 0141-5492. doi:10.1007/s10529-011-0785-3. Процитовано 5 грудня 2021.
- Agrobacterium rhizogenes. NCBI (англ.). Процитовано 5 грудня 2021.
- Veena, Veena; Taylor, Christopher G. (27 листопада 2007). Agrobacterium rhizogenes: recent developments and promising applications. In Vitro Cellular & Developmental Biology - Plant (англ.) 43 (5). с. 383–403. ISSN 1054-5476. doi:10.1007/s11627-007-9096-8. Процитовано 5 грудня 2021.

